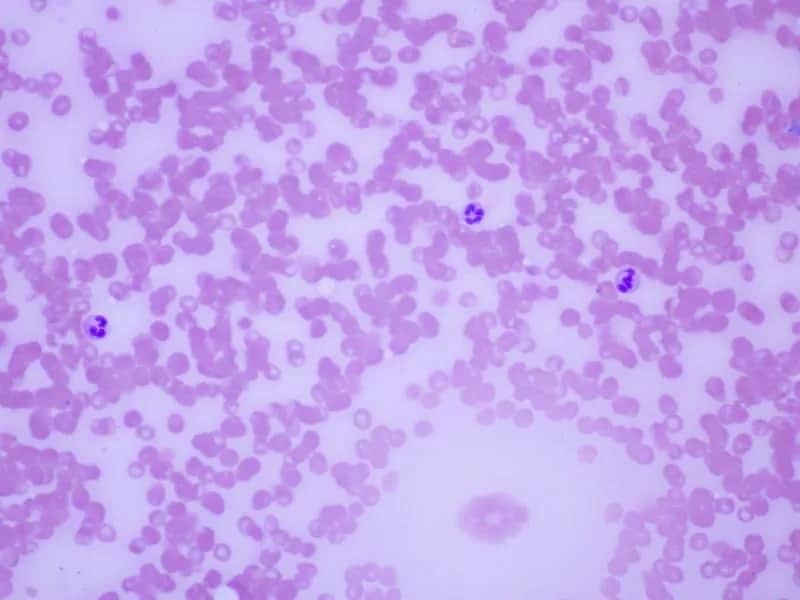
Podwyższony poziom granulocytów w ciąży - co powinno cię zaniepokoić?

Dyżur szpitali Białystok to kluczowa informacja dla mieszkańców potrzebujących pilnej pomocy medycznej. W sytuacjach nagłych często nie wiemy, gdzie i kiedy możemy otrzymać pomoc lekarską. Dlatego przygotowaliśmy dla Ciebie praktyczny przewodnik po dyżurach szpitali w Białymstoku, który pomoże Ci szybko zlokalizować najbliższą placówkę medyczną i sprawdzić godziny jej funkcjonowania.
Najważniejsze informacje:- Wszystkie szpitale w Białymstoku prowadzą całodobowe dyżury na oddziałach ratunkowych (SOR).
- W dni powszednie nocne dyżury rozpoczynają się o 18:00 i trwają do 6:00 następnego dnia.
- Szpital Kliniczny przy ul. M. Skłodowskiej-Curie przyjmuje pacjentów przez całą dobę, siedem dni w tygodniu.
- Przed wizytą warto zadzwonić na infolinię szpitala, aby potwierdzić aktualny dyżur i czas oczekiwania.
- W nagłych przypadkach zawsze możesz wezwać pogotowie ratunkowe pod numerem 112 lub 999.
Dyżur szpitali Białystok to kluczowa informacja dla mieszkańców potrzebujących pilnej pomocy medycznej. W sytuacjach nagłych często nie wiemy, gdzie i kiedy możemy otrzymać pomoc lekarską. Dlatego przygotowaliśmy dla Ciebie praktyczny przewodnik po dyżurach szpitali w Białymstoku, który pomoże Ci szybko zlokalizować najbliższą placówkę medyczną i sprawdzić godziny jej funkcjonowania.
Dyżur szpitali Białystok: godziny przyjęć pacjentów
W Białymstoku funkcjonuje kilka głównych szpitali, które prowadzą dyżury szpitali Białystok w systemie całodobowym. Uniwersytecki Szpital Kliniczny przyjmuje pacjentów przez całą dobę na Szpitalnym Oddziale Ratunkowym, zapewniając kompleksową opiekę medyczną w nagłych przypadkach.
Szpital Wojewódzki im. J. Śniadeckiego oferuje pomoc medyczną w ramach SOR-u oraz prowadzi specjalistyczne dyżury w zakresie chirurgii, interny i pediatrii. Pamiętaj, że w godzinach nocnych (między 18:00 a 6:00) przyjmowani są głównie pacjenci wymagający natychmiastowej pomocy.
Białostockie Centrum Onkologii organizuje dyżury dla pacjentów onkologicznych według specjalnego harmonogramu. W przypadku pogorszenia stanu zdrowia, pacjenci objęci leczeniem onkologicznym mogą zgłaszać się do placówki o każdej porze.
Wojskowy Szpital Kliniczny również prowadzi całodobowe dyżury, ze szczególnym uwzględnieniem pomocy w zakresie ortopedii i traumatologii. W sytuacjach nagłych, szpital przyjmuje wszystkich pacjentów, niezależnie od ich statusu wojskowego.
Lista nocnych dyżurów szpitali Białystok w dni powszednie
Nocne dyżury szpitali Białystok w dni powszednie są zorganizowane w sposób rotacyjny między głównymi placówkami medycznymi. System ten zapewnia mieszkańcom stały dostęp do pomocy medycznej, jednocześnie optymalizując pracę personelu medycznego.
W godzinach nocnych szczególnie ważne jest sprawdzenie, który szpital pełni aktualnie dyżur. Informacje te są dostępne na stronach internetowych poszczególnych placówek oraz w miejskim systemie informacji medycznej.
Każdy szpital dyżurny zapewnia podstawową opiekę medyczną oraz konsultacje specjalistyczne w zakresie najpilniejszych przypadków. Warto pamiętać, że w nocy przyjmowane są głównie przypadki wymagające natychmiastowej interwencji.
Placówki dyżurne dysponują także zespołami ratownictwa medycznego, które mogą zostać wysłane do pacjenta w przypadku zagrożenia życia. W takiej sytuacji należy dzwonić pod numer alarmowy 112 lub bezpośrednio do pogotowia ratunkowego.
- Szpital Kliniczny: dyżury codziennie w godzinach 18:00-6:00
- Szpital Wojewódzki: dyżury w poniedziałki, środy i piątki
- Szpital MSWiA: dyżury we wtorki i czwartki
- Uniwersytecki Dziecięcy Szpital Kliniczny: całodobowe dyżury pediatryczne
- Białostockie Centrum Onkologii: dyżury dla pacjentów onkologicznych
Weekendowe dyżury szpitali Białystok: gdzie po pomoc
W weekendy system dyżurów szpitali Białystok działa według specjalnego harmonogramu. Wszystkie główne szpitale miejskie utrzymują zwiększoną obsadę personelu, aby zapewnić mieszkańcom odpowiedni dostęp do pomocy medycznej.
Szczególnie ważną rolę w weekendy pełni Uniwersytecki Szpital Kliniczny, który zapewnia pełen zakres świadczeń medycznych. SOR przyjmuje pacjentów przez całą dobę, a dodatkowo dostępne są konsultacje specjalistyczne w najważniejszych dziedzinach medycyny.
W soboty i niedziele działa również specjalna infolinia medyczna, gdzie możesz uzyskać informacje o aktualnie dyżurujących placówkach. Operatorzy pomogą Ci wybrać najbardziej odpowiedni szpital, biorąc pod uwagę Twój stan zdrowia i miejsce zamieszkania.
Pamiętaj, że w weekendy mogą występować dłuższe czasy oczekiwania na przyjęcie, szczególnie w przypadku mniej pilnych dolegliwości. Warto wcześniej zadzwonić i upewnić się co do aktualnej sytuacji w wybranej placówce.
Dyżur szpitali Białystok: placówki specjalistyczne
Białostockie placówki specjalistyczne organizują dyżury szpitali Białystok według własnych harmonogramów. Szpital Psychiatryczny prowadzi całodobowy oddział przyjęć dla pacjentów wymagających pilnej pomocy psychiatrycznej, z doświadczonym zespołem lekarzy i psychologów.
Centrum Pediatrii zapewnia specjalistyczną opiekę dla najmłodszych pacjentów. W nagłych przypadkach pediatrycznych, placówka ta powinna być pierwszym wyborem ze względu na specjalistyczny sprzęt i doświadczony personel dziecięcy.
Szpital Ginekologiczno-Położniczy oferuje całodobową opiekę dla kobiet w ciąży oraz w przypadkach nagłych problemów ginekologicznych. Placówka dysponuje nowoczesnym blokiem porodowym i oddziałem patologii ciąży.
W przypadku schorzeń kardiologicznych, Centrum Kardiologii prowadzi całodobowy dyżur hemodynamiczny. Placówka jest przygotowana do natychmiastowych interwencji w przypadku zawałów i innych ostrych zespołów wieńcowych.
- Pamiętaj o zabraniu dokumentacji medycznej i aktualnych wyników badań
- W przypadku przyjmowania leków, zabierz ze sobą ich listę lub opakowania
- Jeśli jesteś pod stałą opieką specjalisty, weź ze sobą kartę informacyjną
- Nie zapomnij o dokumentach tożsamości i potwierdzeniu ubezpieczenia
- W miarę możliwości, poproś kogoś bliskiego o towarzyszenie
Jak dojechać na dyżur szpitali Białystok transportem miejskim
Dostępność komunikacji miejskiej do szpitali pełniących dyżur szpitali Białystok jest kluczowa dla mieszkańców nieposiadających własnego transportu. Większość białostockich szpitali jest dobrze skomunikowana z różnymi częściami miasta poprzez sieć autobusową.
W nocy funkcjonują specjalne linie autobusowe, które zatrzymują się przy najważniejszych placówkach medycznych. Rozkład jazdy jest dostosowany do potrzeb pacjentów i personelu medycznego, ze zwiększoną częstotliwością kursów w godzinach szczytu.
Dla osób starszych i niepełnosprawnych miasto oferuje specjalny transport medyczny, który można zamówić poprzez centralną infolinię. Usługa ta jest szczególnie przydatna w przypadku planowanych wizyt lub gdy stan pacjenta nie wymaga karetki pogotowia.
W bezpośrednim sąsiedztwie szpitali znajdują się przystanki autobusowe i postoje taksówek. Większość placówek posiada również parkingi dla pacjentów, choć w godzinach szczytu znalezienie wolnego miejsca może być utrudnione.

Dyżur szpitali Białystok: numery kontaktowe i rejestracja
Każda placówka pełniąca dyżury szpitali Białystok posiada własną infolinię, gdzie możesz uzyskać szczegółowe informacje o aktualnych dyżurach i czasie oczekiwania. Centralna infolinia miejska działa całodobowo, pomagając w wyborze odpowiedniej placówki.
System rejestracji w szpitalach dyżurnych jest uproszczony, aby zapewnić szybką pomoc w nagłych przypadkach. Nie jest wymagane wcześniejsze umawianie wizyty, choć warto zadzwonić przed przyjazdem, aby upewnić się co do aktualnej sytuacji.
W przypadku planowanych wizyt kontrolnych lub konsultacji specjalistycznych, rejestracja odbywa się standardową drogą - telefonicznie lub przez internet. Pamiętaj, że system dyżurów jest przeznaczony głównie dla przypadków nagłych i pilnych.
Szpitale prowadzą także elektroniczny system informacji o czasie oczekiwania na przyjęcie. Możesz sprawdzić te dane na stronach internetowych placówek lub poprzez specjalną aplikację miejską, co pomoże Ci lepiej zaplanować wizytę.
Podsumowanie
System dyżurów szpitali Białystok zapewnia mieszkańcom miasta całodobowy dostęp do opieki medycznej. Każda placówka pełniąca dyżur dysponuje wykwalifikowanym personelem medycznym, nowoczesnym sprzętem diagnostycznym oraz specjalistycznymi oddziałami, gotowymi do udzielenia pomocy w nagłych przypadkach.
Znajomość harmonogramu dyżuru szpitali Białystok pozwala na szybkie dotarcie do odpowiedniej placówki w sytuacjach wymagających pilnej interwencji lekarskiej. Dzięki rozbudowanej sieci transportu miejskiego oraz systemowi informacji medycznej, pacjenci mogą skutecznie korzystać z całodobowej opieki medycznej.